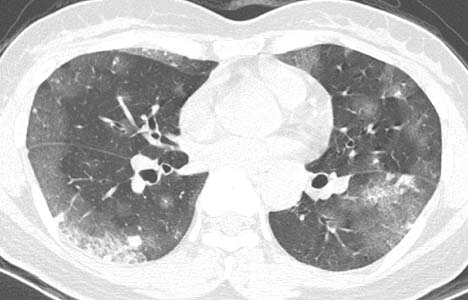

医影在线
标题: DSA0079:[转帖]肝癌TACE后(3)--请CT讨论区战友看过来! [打印本页]
作者: lzdyjg 时间: 2007-1-22 08:15
标题: DSA0079:[转帖]肝癌TACE后(3)--请CT讨论区战友看过来!
(结果公布:http://www.radida.com/bbs/forum.php?mod=viewthread&tid=20391)
患者女性,43岁,肝癌tace治疗后出现胸闷不适.
请分析肺部改变的成因及可能的诊断.






[本贴已被 jiajie 于 2007-1-22 16:13:53 修改过]
[本贴已被 翁志蓬 于 2007-1-28 13:39:54 修改过]
作者: zjzjr 时间: 2007-1-22 21:18
动静脉瘘,栓塞剂经瘘口进入肝静脉--下腔静脉--右心房--右心室--肺动脉--沉积于肺内.
作者: lzdyjg 时间: 2007-1-28 08:30
标题: 回复:dsa0079:[转帖]肝癌tace后(3)--请ct讨论区战友看过来!
原发性肝癌进行栓塞治疗时,若肝动脉造影显示肿瘤侵犯肝静脉,且有明显的肝动静脉瘘,则使用碘油乳剂就不妥当,因为大量碘油可通过瘘道进入肺部,引起肺栓塞的并发症。
此时应在抗癌药物灌注后,先注入明胶海绵条阻塞动静脉瘘,或经颈静脉穿刺置放球囊导管于肝静脉,暂时性阻断肝静脉血流后再考虑用碘油乳剂栓塞,栓塞后加用明胶海绵。
国内颜志平等报道:动物实验表明,碘化油进入肺部致死量约为0.5ml/ kg ,少量碘化油进入肺部可通过肺部吞噬细胞进行“消化”,故少量碘化油进入肺部后一般经过对症处理后,一般不会遗留明显并发症。
感谢zjzjr对dsa0079、0077准确诠释!
[本贴已被 lzdyjg 于 2007-1-28 0:35:02 修改过]
作者: drzhang8888 时间: 2007-6-4 06:14
精彩
作者: 火中金 时间: 2007-6-4 09:44
支持3楼意见,请问:少量碘化油进入肺部后如何对症处理?
作者: jinguoji 时间: 2007-6-8 21:29
谢谢!
作者: flag_wang 时间: 2010-1-21 07:53
谢谢,学习
作者: 健力宝 时间: 2010-4-16 00:45
谢谢,学习
作者: dr.yang 时间: 2012-11-7 23:14
标题: Re:回复:dsa0079:[转帖]肝癌tace后(3)--请ct讨论区战友看过来!
引用第2楼lzdyjg于2007-01-28 08:30发表的 回复:dsa0079:[转帖]肝癌tace后(3)--请ct讨论区战友看过来! :
原发性肝癌进行栓塞治疗时,若肝动脉造影显示肿瘤侵犯肝静脉,且有明显的肝动静脉瘘,则使用碘油乳剂就不妥当,因为大量碘油可通过瘘道进入肺部,引起肺栓塞的并发症。
此时应在抗癌药物灌注后,先注入明胶海绵条阻塞动静脉瘘,或经颈静脉穿刺置放球囊导管于肝静脉,暂时性阻断肝静脉血流后再考虑用碘油乳剂栓塞,栓塞后加用明胶海绵。
国内颜志平等报道:动物实验表明,碘化油进入肺部致死量约为0.5ml/ kg ,少量碘化油进入肺部可通过肺部吞噬细胞进行“消化”,故少量碘化油进入肺部后一般经过对症处理后,一般不会遗留明显并发症。
感谢zjzjr对dsa0079、0077准确诠释!
....... 
| 欢迎光临 医影在线 (http://bbs.radida.com/bbs/) |
Powered by Discuz! X3.2 |